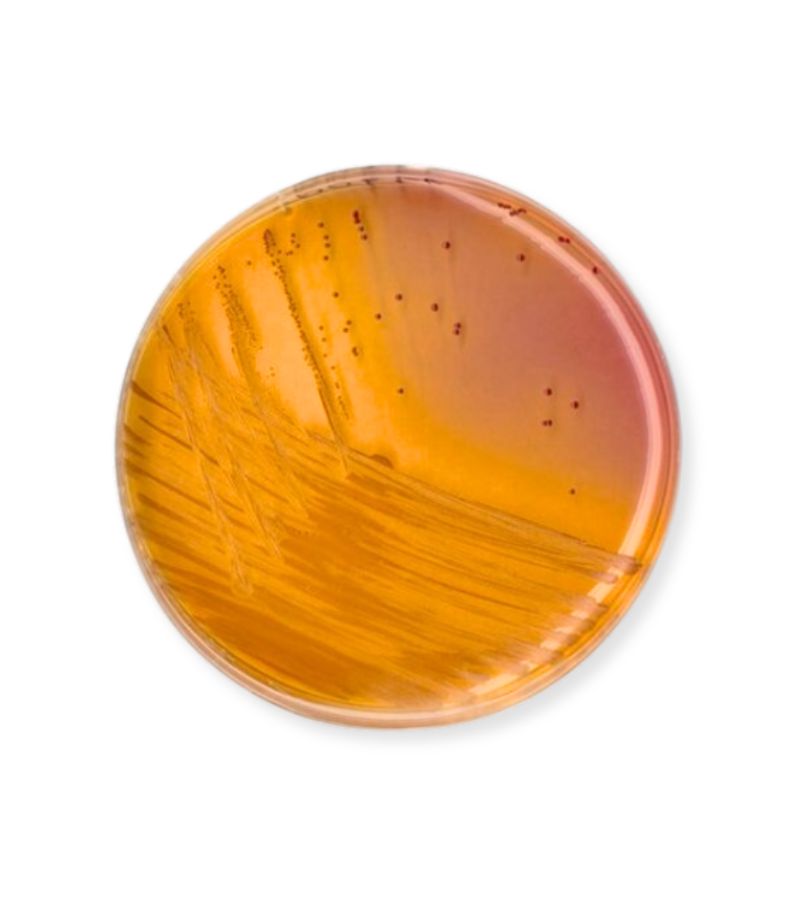
Agar KF para Estreptococos para Microbiología NutriSelect™ plus 500 gr
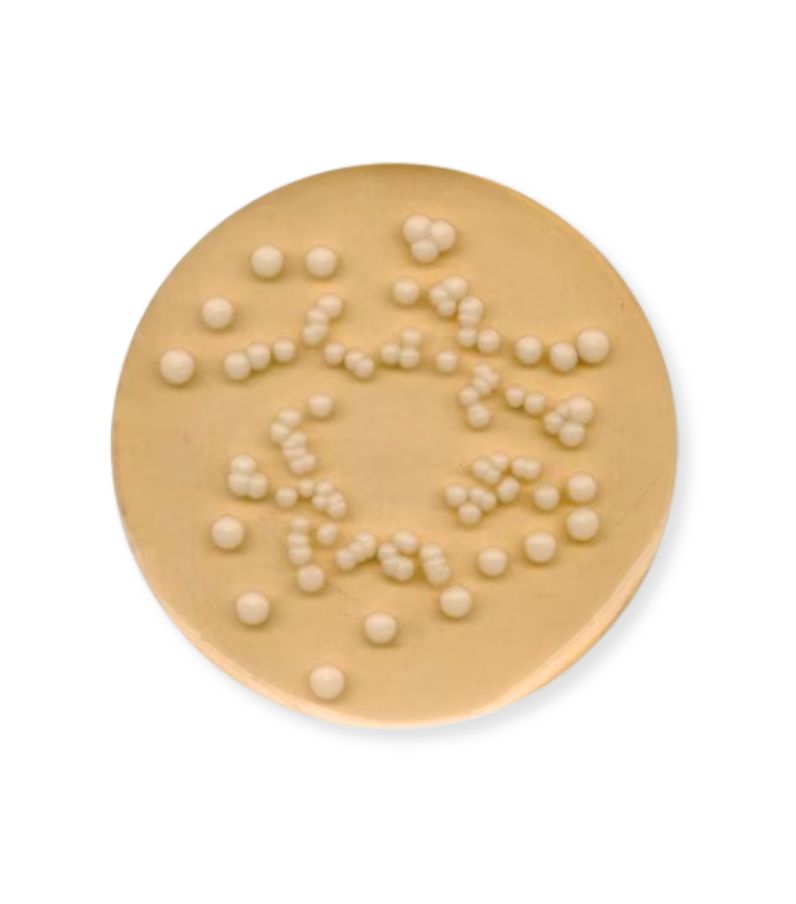
Agar Patata-dextrosa para microbiología GranuCult® prime 500 g

0
0
Productos
- Acuacultura
- Farmacéutica
- Química
- Cosmética y dermocosmética
- Alimentos y bebidas
- Laboratorios de servicios
- Academia y centros de investigación
- Ambiental y suelos
- Clínico y hospitalario
- Aguas y efluentes
Productos
- Acuacultura
- Farmacéutica
- Química
- Cosmética y dermocosmética
- Alimentos y bebidas
- Laboratorios de servicios
- Academia y centros de investigación
- Ambiental y suelos
- Clínico y hospitalario
- Aguas y efluentes